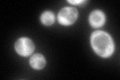
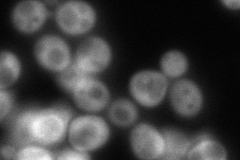
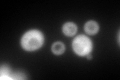
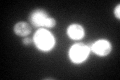
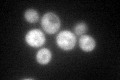

View description
Glutamine tRNA synthetase, monomeric class I tRNA synthetase that catalyzes the specific glutaminylation of tRNA(Glu); N-terminal domain proposed to be involved in enzyme-tRNA interactions
Localization:
Intensity:
Fold change:
Significance:
-
C’ GFP library in SD
cytosol189.84 -
N' NOP1pr-GFP in SD

cytosol222.11 -
N' TEF2pr-mCherry in SD

cytosol289.015 -
N' NATIVEpr-GFP in SD
cytosol179.133 -
N' TEF2pr-VC and Cyto-VN in SD

cytosol92.29 -
C’ GFP library in SD+DTT
cytosol175.470.92No -
C’ GFP library in SD+H2O2
cytosol167.190.88No -
C’ GFP library in Starvation Media
cytosol119.250.62No -
C’ GFP library on the background of Pup2-DaMP

cytosol -
C’ GFP library on the background of CCT mutant

cytosol201.5981.0619No
